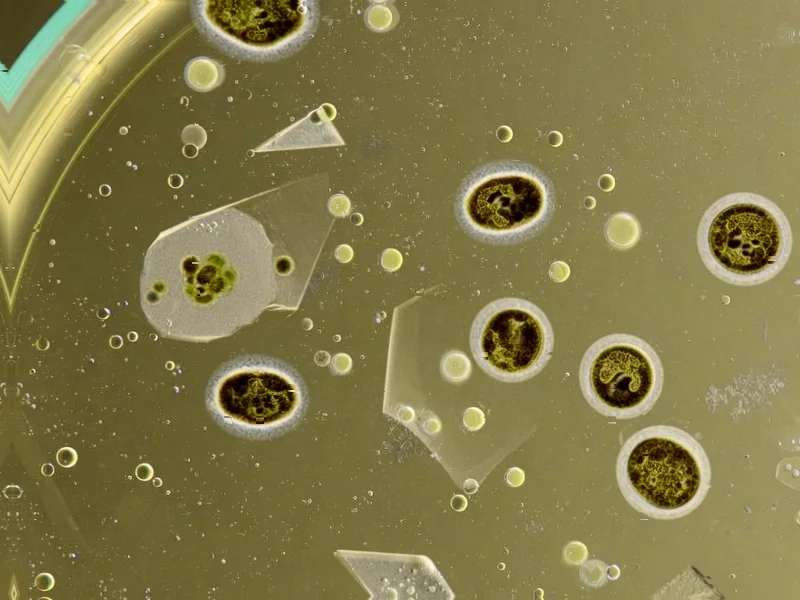
How a Rabbit Droppings Microbe Could Revolutionize Biofuels

How a Rabbit Droppings Microbe Could Revolutionize Biofuels
Researchers have solved the mystery of how an industrial microbe transforms deadly carbon monoxide into biofuel. The discovery could dramatically expand sustainable fuel production from industrial waste gases.